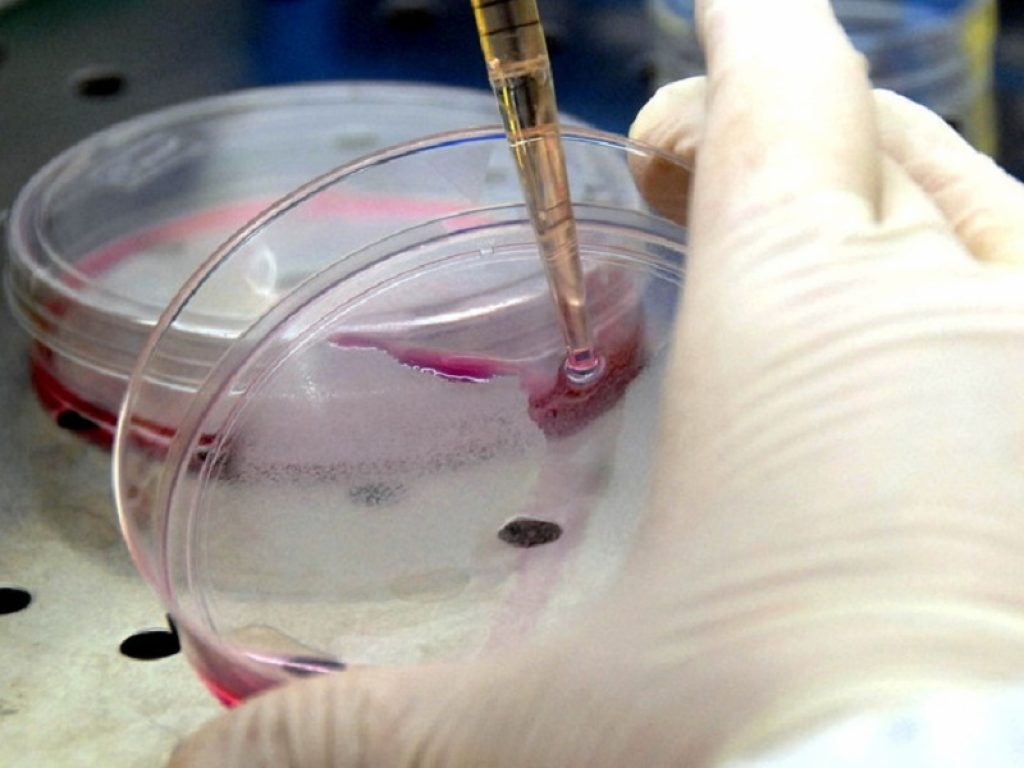
Una molecola estratta dalla lattuga selvatica, una pianta molto comune e non commestibile, potrebbe potenziare le terapie antitumorali contro il glioblastoma

Una molecola estratta dalla lattuga selvatica, una pianta molto comune e non commestibile, potrebbe potenziare le terapie antitumorali contro il glioblastoma
È nota come lattuga selvatica, e non è adatta al consumo alimentare in quanto tossica. Ma questa pianta (nome scientifico Lactuca virosa, dove “virosa” sta, appunto, per velenosa) contiene una molecola che potrebbe costituire un aiuto supplementare nelle terapie antitumorali contro il glioblastoma.
Sono i risultati di una ricerca diretta dalla dottoressa Antonella Arcella, Laboratorio di Neuropatologia Molecolare dell’Unità di Neuropatologia dell’IRCCS Neuromed di Pozzilli, e pubblicata sulla rivista scientifica Molecules. Nel corso dell’esperimento, i ricercatori hanno sottoposto a un trattamento con lactucopicrina uno specifico tipo di cellule del glioblastoma, un tipo di tumore maligno cerebrale particolarmente aggressivo, nonché il più diffuso.
“Il trattamento –delle cellule di glioblastoma dice Arcella, coordinatrice del laboratorio – si è dimostrato efficace utilizzando vari meccanismi. La lactucopicrina è infatti capace sia di arrestare il ciclo cellulare che di indurre apoptosi (la morte programmata delle cellule). Inoltre la stessa molecola è capace di aumentare la sensibilità delle cellule tumorali verso la temozolomide, il chemioterapico di prima scelta contro il glioblastoma. Si è manifestata una sinergia tra il composto naturale e il farmaco. Questo ci fa pensare che la lactucopicrina possa entrare a far parte di una terapia multimodale che, combinando gli effetti della chemioterapia e dell’estratto naturale, possa rappresentare una strada terapeutica più efficiente contro questo insidioso tumore cerebrale”.
Rotondo, Rossella; Oliva, Maria A.; Staffieri, Sabrina; Castaldo, Salvatore; Giangaspero, Felice; Arcella, Antonietta. 2020. “Implication of Lactucopicrin in Autophagy, Cell Cycle Arrest and Oxidative Stress to Inhibit U87Mg Glioblastoma Cell Growth” Molecules 25, no. 24: 5843.